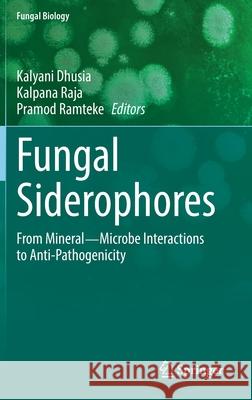
Fungal Siderophores: From Mineral―microbe Interactions to Anti-Pathogenicity Dhusia, Kalyani 9783030530761 Springer

» książki » Science - Life Sciences - Mycology
 |
Fungal Biofilms and Related Infections: Advances in Microbiology, Infectious Diseases and Public Health Volume 3
ISBN: 9783319423593 / Angielski / Twarda / 130 str. Termin realizacji zamówienia: ok. 5-8 dni roboczych. This book covers the latest data available to understand the mechanisms causing the formation of single species fungal biofilms or polymicrobial biofilms involving fungal species; specific chapters present hot topics such as resistance mechanisms and composition and role of the matrix. Moreover, it reviews updated data on biofilms that contain yeasts or filamentous fungi and develop in the human body or in water and may cause infections. The latest available data for both diagnostic and treatment of infections associated to fungi growing in biofilms is also presented. The activity of... This book covers the latest data available to understand the mechanisms causing the formation of single species fungal biofilms or polymicrobial bi... |
cena:
605,23 zł |
 |
Systematics and Evolution: Part a
ISBN: 9783662495780 / Angielski / Miękka / 461 str. Termin realizacji zamówienia: ok. 5-8 dni roboczych. This volume includes treatments of systematics and related topics for both fungi and fungus-like organisms in four eukaryotic supergroups, as well as specialized chapters on nomenclature, techniques and evolution. These organisms are of great interest to mycologists, plant pathologists and others, including those interested in the animal parasitic Microsporidia. Our knowledge of the systematics and evolution of fungi has made great strides since the first edition of this volume, largely driven by molecular phylogenetic analyses. Consensus among mycologists has led to a stable systematic... This volume includes treatments of systematics and related topics for both fungi and fungus-like organisms in four eukaryotic supergroups, as well ... |
cena:
823,13 zł |
 |
Giant Polypores and Stoned Reindeer: Rambles in Kingdom Fungi
ISBN: 9780982821930 / Angielski / Miękka / 146 str. Termin realizacji zamówienia: ok. 5-8 dni roboczych. |
cena:
65,14 zł |
 |
The Cyclic Peptide Toxins of Amanita and Other Poisonous Mushrooms
ISBN: 9783319768212 / Angielski / Twarda / 245 str. Termin realizacji zamówienia: ok. 5-8 dni roboczych. To maximize the broad utility and appeal of the book, care has been taken to define all technical terms specific to a particular discipline, so that, for example, mycologists will be able to understand the relevant chemistry, and chemists will be able to understand the relevant fungal biology.
To maximize the broad utility and appeal of the book, care has been taken to define all technical terms specific to a particular discipline, so that, ...
|
cena:
645,58 zł |
 |
Growth, Differentiation and Sexuality
ISBN: 9783319798509 / Angielski / Miękka / 521 str. Termin realizacji zamówienia: ok. 5-8 dni roboczych. |
cena:
1412,26 zł |
 |
Biochemistry and Molecular Biology
ISBN: 9783319802176 / Angielski / Miękka / 397 str. Termin realizacji zamówienia: ok. 5-8 dni roboczych. |
cena:
806,99 zł |
 |
Biology of Microfungi
ISBN: 9783319804989 / Angielski / Miękka / 650 str. Termin realizacji zamówienia: ok. 5-8 dni roboczych. |
cena:
665,76 zł |
 |
Advances and Applications Through Fungal Nanobiotechnology
ISBN: 9783319827117 / Angielski / Miękka / 340 str. Termin realizacji zamówienia: ok. 5-8 dni roboczych. |
cena:
605,23 zł |
 |
Concise Mushroom Guide
ISBN: 9781472963789 / Angielski / Miękka / 192 str. Termin realizacji zamówienia: ok. 5-8 dni roboczych. |
cena:
40,31 zł |
 |
Fungal Biofilms and Related Infections: Advances in Microbiology, Infectious Diseases and Public Health Volume 3
ISBN: 9783319825595 / Angielski / Miękka / 130 str. Termin realizacji zamówienia: ok. 5-8 dni roboczych. |
cena:
605,23 zł |
 |
Mycorrhizal Networks
ISBN: 9789402408225 / Angielski / Miękka / 286 str. Termin realizacji zamówienia: ok. 5-8 dni roboczych. |
cena:
685,93 zł |
 |
The Cyclic Peptide Toxins of Amanita and Other Poisonous Mushrooms
ISBN: 9783030082994 / Angielski / Miękka / 245 str. Termin realizacji zamówienia: ok. 5-8 dni roboczych. |
cena:
645,58 zł |
 |
Slime Mould in Arts and Architecture
ISBN: 9788770220729 / Angielski / Twarda / 310 str. Termin realizacji zamówienia: ok. 5-8 dni roboczych. |
cena:
375,54 zł |
 |
Recent Developments on Genus Chaetomium
ISBN: 9783030316112 / Angielski / Twarda / 452 str. Termin realizacji zamówienia: ok. 5-8 dni roboczych. |
cena:
605,23 zł |
 |
Immunological Methods in Microbiology: Volume 47
ISBN: 9780128208113 / Angielski / Twarda / 410 str. Termin realizacji zamówienia: ok. 5-8 dni roboczych. |
cena:
678,01 zł |
 |
Agriculturally Important Fungi for Sustainable Agriculture: Volume 1: Perspective for Diversity and Crop Productivity
ISBN: 9783030459703 / Angielski / Twarda / 300 str. Termin realizacji zamówienia: ok. 5-8 dni roboczych. |
cena:
605,23 zł |
 |
Agriculturally Important Fungi for Sustainable Agriculture: Volume 2: Functional Annotation for Crop Protection
ISBN: 9783030484736 / Angielski / Twarda / 370 str. Termin realizacji zamówienia: ok. 5-8 dni roboczych. |
cena:
605,23 zł |
 |
Genetics and Biotechnology
ISBN: 9783030499235 / Angielski / Twarda / 452 str. Termin realizacji zamówienia: ok. 5-8 dni roboczych. |
cena:
726,29 zł |
|
Fungal Siderophores: From Mineral―microbe Interactions to Anti-Pathogenicity
ISBN: 9783030530761 / Angielski / Twarda / 216 str. Termin realizacji zamówienia: ok. 5-8 dni roboczych. |
cena:
685,93 zł |
 |
Trichoderma Reesei: Methods and Protocols
ISBN: 9781071610473 / Angielski / Twarda / 364 str. Termin realizacji zamówienia: ok. 5-8 dni roboczych. |
cena:
605,23 zł |













